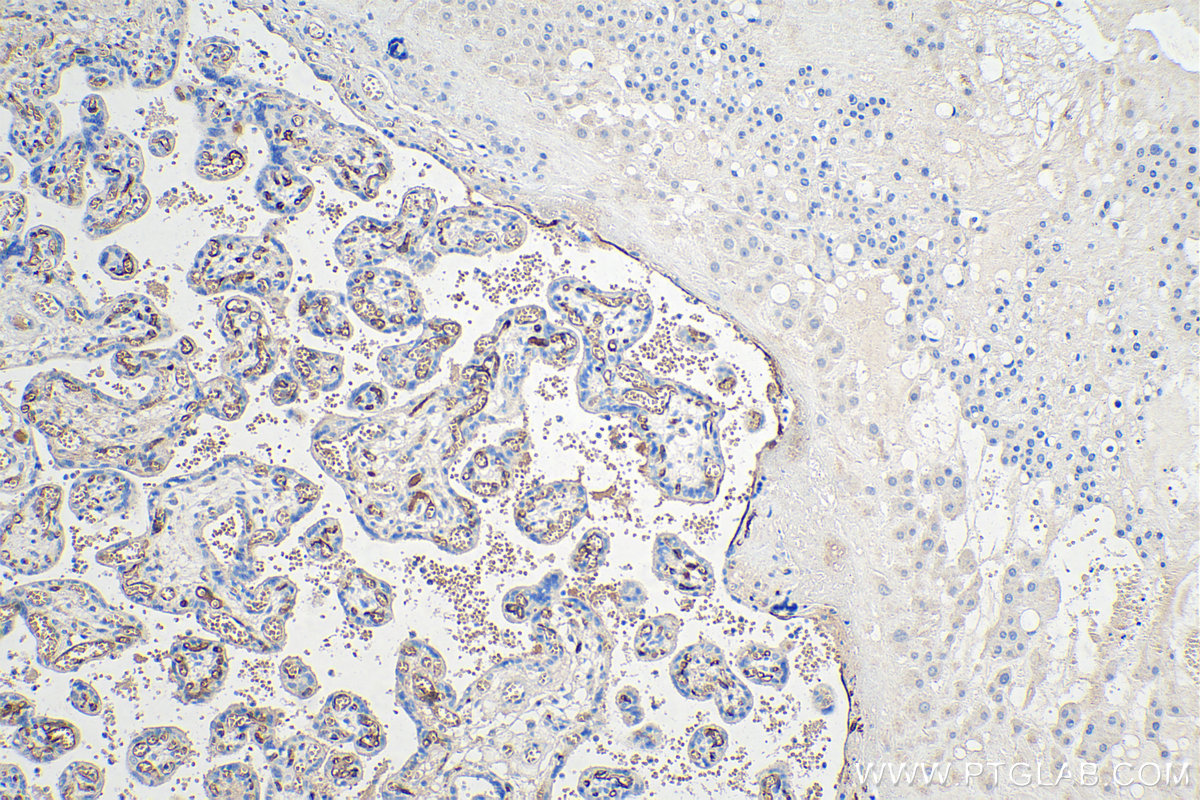

验证数据展示
经过测试的应用
| Positive WB detected in | human adipose tissue |
| Positive IHC detected in | rat brown adipose tissue, human placenta tissue, human prostate cancer tissue, mouse brown adipose tissue, mouse skeletal muscle tissue, mouse skin tissue Note: suggested antigen retrieval with TE buffer pH 9.0; (*) Alternatively, antigen retrieval may be performed with citrate buffer pH 6.0 |
| Positive IF/ICC detected in | 3T3-L1 cells, human adipose-derived mesenchymal stem cells |
推荐稀释比
| 应用 | 推荐稀释比 |
|---|---|
| Western Blot (WB) | WB : 1:500-1:2000 |
| Immunohistochemistry (IHC) | IHC : 1:200-1:800 |
| Immunofluorescence (IF)/ICC | IF/ICC : 1:200-1:800 |
| It is recommended that this reagent should be titrated in each testing system to obtain optimal results. | |
| Sample-dependent, Check data in validation data gallery. | |
产品信息
66239-1-Ig targets Adiponectin in WB, IHC, IF/ICC, ELISA applications and shows reactivity with human, mouse, rat samples.
| 经测试应用 | WB, IHC, IF/ICC, ELISA Application Description |
| 文献引用应用 | WB, IF |
| 经测试反应性 | human, mouse, rat |
| 文献引用反应性 | human, mouse, pig |
| 免疫原 |
CatNo: Ag17383 Product name: Recombinant human ADIPOQ protein Source: e coli.-derived, PET28a Tag: 6*His Domain: 1-244 aa of BC096308 Sequence: MLLLGAVLLLLALPGHDQETTTQGPGVLLPLPKGACTGWMAGIPGHPGHNGAPGRDGRDGTPGEKGEKGDPGLIGPKGDIGETGVPGAEGPRGFPGIQGRKGEPGEGAYVYRSAFSVGLETYVTIPNMPIRFTKIFYNQQNHYDGSTGKFHCNIPGLYYFAYHITVYMKDVKVSLFKKDKAMLFTYDQYQENNVDQASGSVLLHLEVGDQVWLQVYGEGERNGLYADNDNDSTFTGFLLYHDTN 种属同源性预测 |
| 宿主/亚型 | Mouse / IgG1 |
| 抗体类别 | Monoclonal |
| 产品类型 | Antibody |
| 全称 | adiponectin, C1Q and collagen domain containing |
| 别名 | ADIPOQ, 30 kDa adipocyte complement-related protein, 5D8A7, Adipocyte complement-related 30 kDa protein, Adipocyte, C1q and collagen domain-containing protein |
| 计算分子量 | 244 aa, 26 kDa |
| 观测分子量 | 29 kDa |
| GenBank蛋白编号 | BC096308 |
| 基因名称 | Adiponectin |
| Gene ID (NCBI) | 9370 |
| RRID | AB_2881628 |
| 偶联类型 | Unconjugated |
| 形式 | Liquid |
| 纯化方式 | Protein G purification |
| UNIPROT ID | Q15848 |
| 储存缓冲液 | PBS with 0.02% sodium azide and 50% glycerol, pH 7.3. |
| 储存条件 | Store at -20°C. Stable for one year after shipment. Aliquoting is unnecessary for -20oC storage. |
背景介绍
Adiponectin (AdipoQ), an adipocyte-derived hormone, is one of the most abundant adipokines in the blood circulation. Adiponectin modulates a number of metabolic processes, including improving INS sensitivity and anti-inflammatory activity. The role of AdipoQ in reproduction is not yet fully understood, but the expression of AdipoQ in reproductive tissues has been observed in various animals and humans, including chicken testis, bovine ovary, and human placenta. Adiponectin exerts its effects by activating a range of different signaling molecules via binding to two transmembrane AdipoQ receptors, AdipoR1 and AdipoR2. AdipoR1 is expressed primarily in the skeletal muscle, whereas AdipoR2 is predominantly expressed in the liver. AdipoQ May play a role in cell growth, angiogenesis and tissue remodeling by binding and sequestering various growth factors.
实验方案
| Product Specific Protocols | |
|---|---|
| IF protocol for Adiponectin antibody 66239-1-Ig | Download protocol |
| IHC protocol for Adiponectin antibody 66239-1-Ig | Download protocol |
| WB protocol for Adiponectin antibody 66239-1-Ig | Download protocol |
| Standard Protocols | |
|---|---|
| Click here to view our Standard Protocols |
发表文章
| Species | Application | Title |
|---|---|---|
J Cell Physiol Rapid responses of adipocytes to iron overload increase serum TG level by decreasing adiponectin. | ||
Food Funct Quercetin regulates skeletal muscle fiber type switching via adiponectin signaling. | ||
Anim Biotechnol Effect of dietary leucine supplementation on skeletal muscle fiber type transformation in weaning piglets | ||
Anim Biotechnol Leucine regulates porcine muscle fiber type transformation via adiponectin signaling pathway. | ||
Chem Biol Interact Inhibitory effects of black phosphorus nanosheets on tumor cell proliferation through downregulation of ADIPOQ and downstream signaling pathways | ||
Signal Transduct Target Ther Annexin A1 binds PDZ and LIM domain 7 to inhibit adipogenesis and prevent obesity |